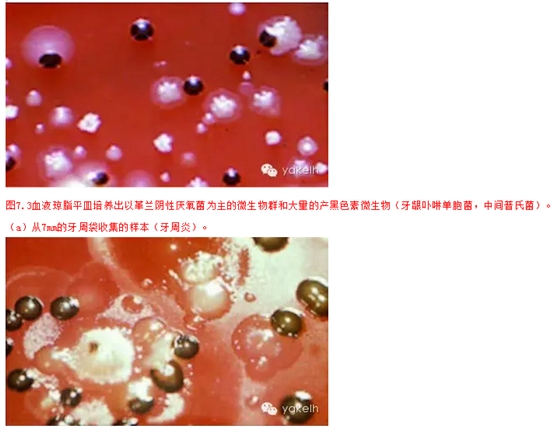
81.png

病因:微生物
生物膜的形成
¤¤牙種植體像牙齒一樣處于流體系統(tǒng)中,并且具有硬的、不會脫落的表面。因此,它們也會形成生物膜。糖蛋白將會吸附到暴露在口腔環(huán)境中的種植體表面。在種植體植入幾分鐘到幾小時后,單一的細菌菌落便會粘附于種植體表面獲得性膜(圖7.1)。接下來,這些菌落分裂并形成更大的更具有膨脹性的口腔細菌共聚體。早期定植的通常主要是革蘭陽性球菌和桿菌。隨著時間推移,生物膜將發(fā)展成更為復雜的微生物群,該微生物群的成分取決于整個口腔生態(tài)系統(tǒng)的微生物(圖7.2)。

種植體周圍微生物群的發(fā)展
微生物群在無牙頜患者的自然定植
¤¤關于種植體周圍牙齦溝微生物發(fā)展的第一個研究是使用厭氧培養(yǎng)技術在無牙頜患者上進行的。顯然,在無牙頜患者的種植體周圍牙齦溝定植的微生物來源于懸浮在唾液中的微生物,并不受已經存在于牙齦溝或牙周袋微生物的影響。在一期穿黏膜種植體植入前,在無牙嵴上收集黏膜拭子樣本。隨后,在頭2個月內,每隔1周用無菌紙尖收集一次樣品,在后4個月,每隔1個月用無菌紙尖收集一次樣品。結果發(fā)現,在一期穿黏膜種植體植入后2周就有微生物群定植在種植體周圍牙齦溝,微生物群主要以革蘭陽性兼性細菌,與健康牙齦或牙齦炎時齦溝內微生物群非常相似。但是,有一名曾經由于種植體周感染導致種植體失敗的患者,在一期穿黏膜種植體植入后120天,種植體周圍牙齦溝內檢測出較高比例的革蘭陰性厭氧菌和螺旋菌。從臨床角度講,這些微生物群的出現是炎癥加重和感染的早期征兆,該患者需要抗感染治療。
微生物群在部分牙缺失患者的定植
¤¤關于在部分牙缺失患者種植體周圍牙齦溝的微生物定植的前瞻性研究很少。顯然,剩余牙的牙周袋具有高比例的可疑牙周致病菌,可能影響種植體周圍牙齦溝的微生物定植。一項研究是一階段式穿黏膜種植體植入后3個月與6個月和另一項是兩階段式埋入式種植體的基臺連接后,證實在剩余牙的牙周袋發(fā)現的細菌也會定植在種植體周圍牙齦溝內。如果牙周致病菌在牙周袋被發(fā)現,種植體植入3個月后同樣也會檢測出該致病菌。因此,這就意味著在生物膜發(fā)展的過程中,微生物定植類型很大程度上受口腔環(huán)境內不同生態(tài)環(huán)境的定植細菌影響。因此,對于在種植體周圍牙齦溝病原微生物群的建立,未治療的牙周炎可能具有較高的風險。
¤¤最近,通過棋盤核酸分子雜交技術研究了種植體植入后30分鐘和手術后1~12周早期細菌定植的情況。種植體周圍牙齦溝的微生物定植發(fā)生在種植體植入后30分鐘內。此外,種植體和牙齒表面的定植微生物不同。這與許多關于發(fā)生在植入手術1 0~14天的種植體表面微生物定植研究結果一致。
與種植體周圍感染相關的微生物群
¤¤相關研究已經證實在種植體周齦溝或袋內微生物群的組成,無論周邊是正?;蜓装Y的黏膜組織。最初,細菌的形態(tài)是通過電子顯微鏡和暗視野顯微鏡確定的。后來,厭氧菌養(yǎng)技術用于研究不同條件下種植體周的微生物群?;旧?,健康的種植體周圍組織或黏膜的相關微生物群分別類似于健康牙齦或牙齦炎的微生物群。與此相反,在許多情況下,但并非所有情況下,種植體周圍感染中確定的微生物群與進展期牙周炎牙周袋的微生物群是一致的(圖 7.3)。微生物群在鈦種植體表面和牙表面定植可能還是存在差異。因為在牙周微生物研究中通常不被認為是致病菌的金黃色葡萄球菌[15]現被認為對鈦表面的生物膜有很強的粘附能力。高比例的醫(yī)用植入體已經成為植入裝置相關感染的焦點。這種感染很難消除,因為導致感染的細菌生存在發(fā)育良好和具有保護性的生物膜內。金黃色葡萄球菌自溶素可能是包括口腔鈦種植體在內的植入體微生物早期定植的重要促進因素。
種植體周圍組織病的發(fā)病機制
¤¤1993年第一次歐洲牙周病學研討會確定并定義了兩種類型的口腔種植體相關的病變。種植體周圍黏膜炎是指局限于種植體周圍的黏膜可逆性炎癥(圖7.4)。種植體周圍炎是指侵犯已建立骨結合且行使功能的種植體周組織的炎性過程,并可導致支持骨的喪失(圖 7.5)。

圖7.5 種植體周圍炎。(a)在無牙下頜患者的左下尖牙區(qū)域的種植體發(fā)生種植體周圍炎的臨床表現,與之對照的還有下頜第二磨牙區(qū)域的種植體具有健康或黏膜感染的種植體周圍組織的臨床表現。

圖7.5 種植體周圍炎。(c)進展期種植體周圍炎的病變。

圖7.5 種植體周圍炎。(e)病損的高倍鏡顯示在種植體表面的生物膜。
種植體周圍黏膜炎
動物模型
¤¤種植體新生生物膜的形成和宿主反應已經在小獵犬動物模型上通過組織學技術研究過。研究發(fā)現在細菌刺激下,炎性浸潤發(fā)展在鄰近對照牙和口腔種植體周圍組織是一樣的,說明牙齦對細菌定植的宿主反應和種植體周圍黏膜是相同的。
人體研究
¤¤種植體周圍軟組織封閉的局部防御機制已經被研究,并且與牙-牙齦單元的局部防御機制做了比較。在兩種軟組織成分中產生的炎癥介質和細胞因子非常相似。并且,最初由L e等描述的實驗性牙齦炎模型和作為生物膜形成與牙齦炎發(fā)展之間因果關系的最終證據同樣可用到種植體周病上。一個兩階段埋入式的種植體系統(tǒng)的基臺連接后,經過為期6個月細致的菌斑控制,患者被要求中止所有的口腔衛(wèi)生措施3周。3周后,對照的牙齦組和種植體周圍黏膜位點的所有臨床指標沒有顯著性差異(圖7.6)。由于菌斑積累不斷增加,兩種軟組織均表現出牙齦指數增加和探診深度增加,因此,菌斑和黏膜炎發(fā)展的因果效應也在口腔種植體上得到驗證。
圖7.6男性患者的實驗性種植體黏膜炎。未進行口腔衛(wèi)生措施3周內的臨床指標,造成了牙齦炎和黏膜炎的發(fā)展。生物膜發(fā)展和宿主反應之間的因果關系的建立。(a)PLI:菌斑指數。

圖7.6男性患者的實驗性種植體黏膜炎。未進行口腔衛(wèi)生措施3周內的臨床指標,造成了牙齦炎和黏膜炎的發(fā)展。生物膜發(fā)展和宿主反應之間的因果關系的建立。(b) SBI:齦溝出血指數。

種植體周圍炎
¤¤鑒于倫理考慮,種植體周圍感染的實驗性研究不能進行人體試驗。因此,這方面的信息收集必須依賴于動物實驗。不幸的是,以前關于種植體周圍炎的研究對于種植體病損的進展速度和范圍的結果是矛盾的。盡管有一個初步研究提出相對天然牙而言,種植體位點的疾病有一個更緩慢的進展速度。一系列的小獵犬的研究[24]警示種植體周圍病損可能直接發(fā)展到牙槽骨,而牙周炎病損總是先發(fā)生在有完整牙周纖維的牙槽嵴上區(qū)域。
¤¤其他研究組的研究人員在猴模型上通過絲線結扎導致菌斑積聚誘導出種植體周圍炎和牙周炎,并且與通過自然菌斑積聚誘導的兩種疾病的發(fā)生過程進行比較。絲線結扎導致菌斑積聚誘導的天然牙周圍的臨床指標如菌斑指數、牙齦指數、牙周袋深度和附著喪失的增加與絲線結扎導致菌斑積聚誘導的種植體周圍炎位點的臨床指標的增加幅度一致。8個月后,附著喪失接近3.5mm,而在同樣的時間內僅暴露在自然菌斑積聚的種植體的附著喪失不超過0.5mm。絲線結扎導致菌斑積聚誘導的牙周圍鑒定出的微生物群也與絲線結扎導致菌斑積聚誘導的種植體周圍的微生物群相同。此外,8個月后兩種病損通過組織學分析表現極為相似,且出現了骨內缺損(圖 7.5)。數字減影成像術(DSR)顯示,絲線結扎導致菌斑積聚誘導的牙和種植體周有骨密度的喪失和骨內病損的發(fā)展,而在整個實驗階段自然菌斑積聚的種植體周牙槽骨的高度和密度沒有顯著改變。因此,這就意味著重度菌斑積累和一個足夠長的時間可以發(fā)展成為感染,病菌會逐漸侵襲到種植體周圍的支持組織就像在牙周一樣。然而,不是所有的種植體周圍黏膜炎位點都會發(fā)展成為種植體周圍炎,就像不是所有的牙齦炎位點都會發(fā)展成牙周炎一樣。
¤¤對實驗狗組織樣本的組織病理學檢查顯示,牙周位點和種植體位點炎癥病損的大小和位置明顯不同。在牙周位點,病損和牙槽骨間會被非炎癥性的結締組織區(qū)隔離,而種植體周圍組織病損在大多數情況下卻會擴展和侵入牙槽骨的骨髓腔。
¤¤我們可以得出的結論是牙周組織和種植體周圍組織的炎癥的擴散類型不同。菌斑相關的牙周炎病損會被局限在結締組織中,而種植體周圍的病損會侵入牙槽骨。與牙周組織相反,在種植體周圍組織,進展的、菌斑相關的病損似乎很難被局限以消除,可以擴展到邊緣的骨組織內,進一步發(fā)展最終導致種植體失敗。用狗模型進一步研究,觀察不同時期的組織破壞,已經證實這個結論。
本文摘自yakelh微信平臺


